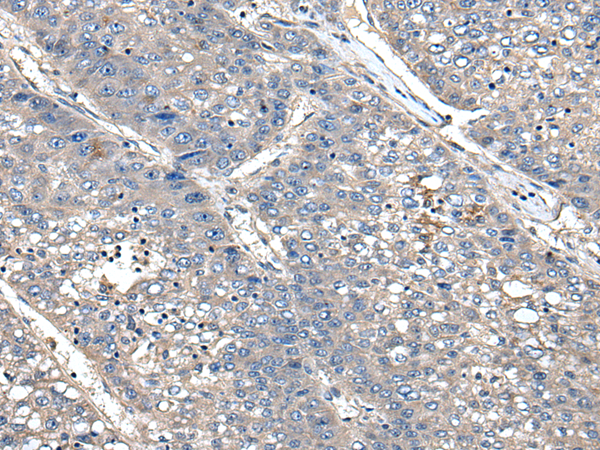

中文名稱:兔抗XDH多克隆抗體
英文名稱: Anti-XDH rabbit polyclonal antibody
別 名: XO; XOR
相關(guān)類別: 一抗
儲 存: 冷凍(-20℃)
宿 主: Rabbit
抗 原: XDH
反應(yīng)種屬: Human, Mouse, Rat
標(biāo) 記 物: Unconjugate
克隆類型: rabbit polyclonal
技術(shù)規(guī)格
|
Background: |
Xanthine dehydrogenase belongs to the group of molybdenum-containing hydroxylases involved in the oxidative metabolism of purines. The encoded protein has been identified as a moonlighting protein based on its ability to perform mechanistically distinct functions. Xanthine dehydrogenase can be converted to xanthine oxidase by reversible sulfhydryl oxidation or by irreversible proteolytic modification. Defects in xanthine dehydrogenase cause xanthinuria, may contribute to adult respiratory stress syndrome, and may potentiate influenza infection through an oxygen metabolite-dependent mechanism. |
|
Applications: |
ELISA, IHC |
|
Name of antibody: |
XDH |
|
Immunogen: |
Synthetic peptide of human XDH |
|
Full name: |
xanthine dehydrogenase |
|
Synonyms: |
XO; XOR |
|
SwissProt: |
P47989 |
|
ELISA Recommended dilution: |
5000-10000 |
|
IHC positive control: |
Human liver cancer |
|
IHC Recommend dilution: |
25-100 |
購物車
幫助
021-54845833/15800441009
